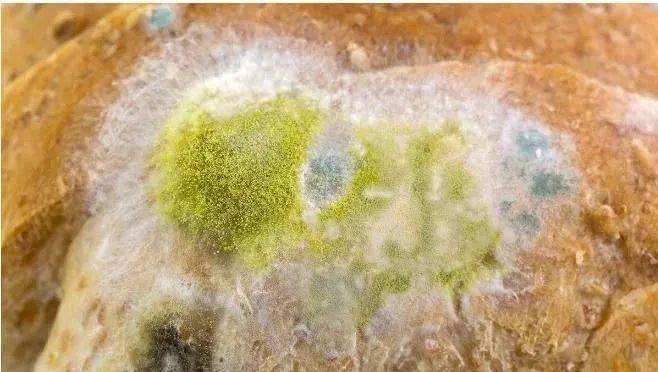
走开米酵菌酸黄曲霉毒素

米酵菌酸致死量

米酵菌酸
图片尺寸1080x1906
上面惨案的背后,其实都隐藏着同一个凶手——米酵菌酸,它的致死率高达
图片尺寸1080x810
高压蒸煮不能破坏米酵菌酸毒性 米酵菌酸中毒病死率达40%以上
图片尺寸449x763
新时代文明实践惠来开展米酵菌酸知识科普宣传活动
图片尺寸650x460
致2死台湾餐厅食物中毒最新进展厨师手部及刀具砧板查出米酵菌酸
图片尺寸720x509
酸汤子中毒事件米酵菌酸究竟有多毒
图片尺寸530x376
并对该毒素的理化性质和致毒机制进行了大量研究,近年来米酵菌酸又
图片尺寸720x681
什么是米酵菌酸?
图片尺寸487x696
致命河粉致一食客身亡慎防米酵菌酸毒素中毒
图片尺寸469x385
酸汤子事件最后一名伤者去世,米酵菌酸怎么这么毒?
图片尺寸1080x732
走开米酵菌酸黄曲霉毒素
图片尺寸658x372
高温都杀不死的米酵菌酸到底有多可怕,速转到相亲相爱一家人群!
图片尺寸640x534
食物中留存的隐患,致命的米酵菌酸是什么样的存在
图片尺寸657x370
9人聚餐8人死亡的真凶米酵菌酸究竟有多毒
图片尺寸689x390
酸汤子事件最后一名伤者去世,米酵菌酸怎么这么毒?
图片尺寸1080x538
黑龙江酸汤子9人聚餐8人死亡事件原因找到了什么是米酵菌酸
图片尺寸555x596
鸡西酸汤子中毒已致9人死亡系米酵菌酸引起米酵菌酸是什么哪些食物
图片尺寸495x597
有医学研究者专门做过"米酵菌酸"致死量的研究.
图片尺寸1080x720
米酵菌酸这种毒素目前在医学上还没有特效的"解药"通常只能通过血液
图片尺寸800x416
酸汤子中毒事件,米酵菌酸有多毒?这些家常菜也可能中招,慎食用
图片尺寸542x316